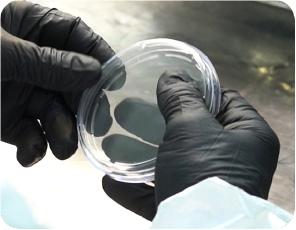

Sala de Bioseguridad
Producción en sala sanitizada y productos esterilizados por ionización

Calidad y seguridad


Profesionales especializados

Auditorías y controles
Certificaciones
Características de la sala
Construida en la década del 90, nuestra sala cuenta con el equipamiento y la tecnología adecuada para garantizar condiciones sanitarias óptimas durante la producción.
+40.000
Cucharas fabricadas por día
+12.000
Placas de Petri para laboratorios por día
+70.000
Productos realizados en la sala diariamente


Placas de Petri
Rafaela Lab
Laboratorios
Este producto nace de la necesidad puntual de un cliente y hoy ya llevamos más de 2 millones de placas vendidas.
Fabricadas en Poliestireno Cristal (PS), cuentan con unos pequeños sobrerrelieves en la cara interior de la tapa para asegurar una ventilación óptima, apoyos en la base para mayor estabilidad durante su uso y un proceso de esterilización por ionizado, el método más seguro para eliminar cualquier carga microbiológica previa.
Industria alimentaria
Laboratorios
Cucharas para leche en polvo
SanCor
Industria Láctea
Tubo para muestras
Industria Alimenticia
Industria Láctea
Preguntas frecuentes
Trabajemos juntos
Contamos con 47 años de experiencia y un fuerte compromiso con el servicio, estamos para escucharte y acompañarte en cada paso del proceso.